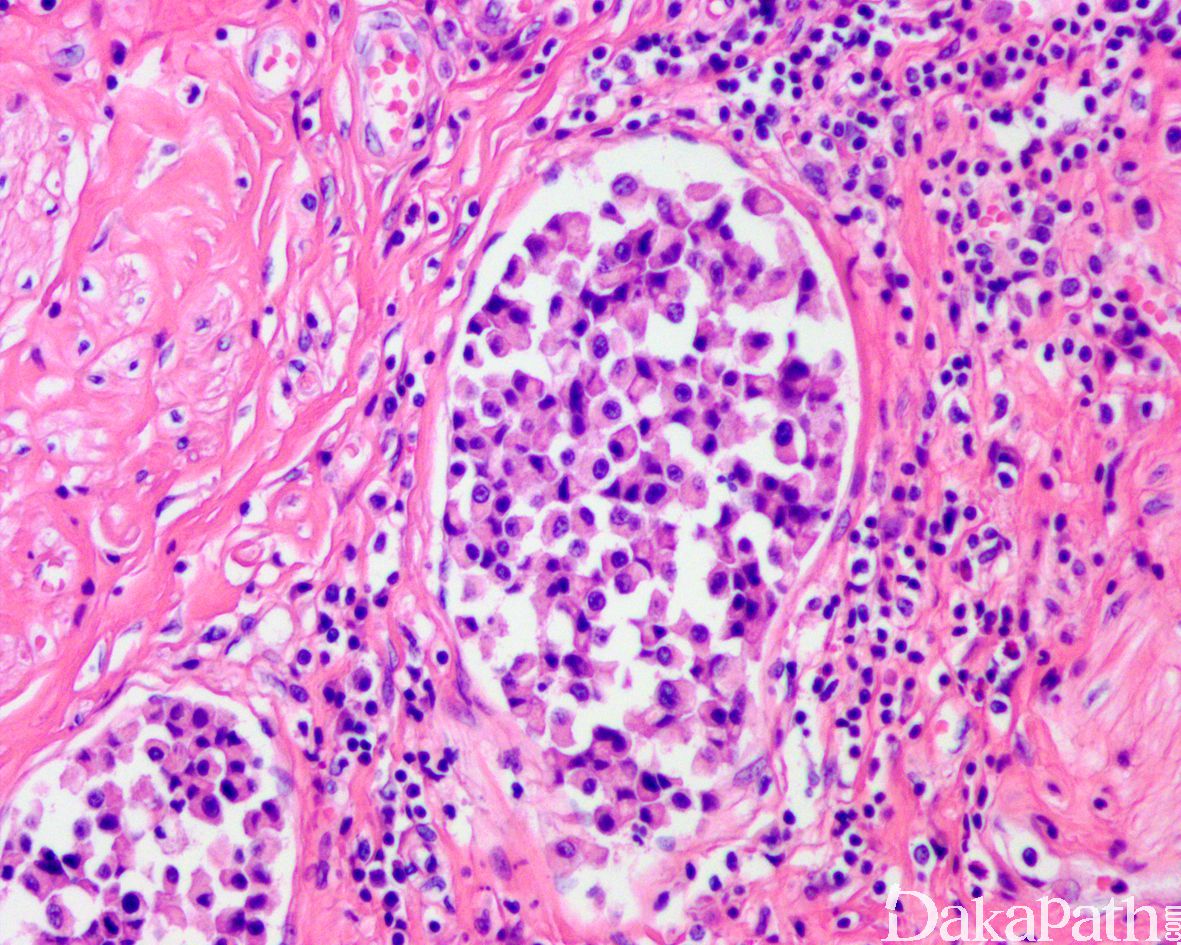

浆细胞样浸润性尿路上皮癌
Infiltrating urothelial carcinoma,Plasmacytoid / signet ring cell
同义词(或曾用名): 印戒细胞尿路上皮癌;浸润性尿路上皮癌,浆细胞样、印戒细胞、弥漫性
概述:
具有浆细胞样、印戒细胞样形态的浸润性尿路上皮癌亚型
发病部位: 膀胱、输尿管、肾盂、尿道
诊断要点:
罕见,占所有尿路上皮癌的比例不超过 5%;大体上表现为单发或多发性肿块,弥漫浸润膀胱壁使膀胱增厚,产生类似于皮革胃样的大体表现;
组织学表现为在疏松或黏液样间质中出现弥漫性排列的单个肿瘤细胞;
肿瘤细胞胞质透亮或嗜酸性,核大、中位或偏位,具有小核仁,似浆细胞或淋巴细胞,多形性不明显;
少数病例肿瘤细胞似印戒细胞,但与细胞外黏液无关,也称为印戒细胞样尿路上皮癌; 5.50%病例可找到高级别的普通型浸润性尿路上皮癌成分;
部分病例可见原位尿路上皮癌或乳头状尿路上皮癌,部分病例的表面黏膜可完全正常;
常见脉管内癌栓。浆细胞样尿路上皮癌可沿着筋膜播散并浸润至腹膜,因此应对肿瘤进行广泛的取材。
免疫组织化学染色:
浆细胞样尿路上皮癌与普通的尿路上皮癌具有相似的免疫表型特征表达 GATA3(80%),P63(45%),CK7( 92%),CK20(70%)。由于 CDH1 基因突变,浆细胞样尿路上皮癌常出现 E-cadherin 表达缺失。少数可表达 GCDFP15,PR,CDX2 等。部分可表达 CD128,需要与浆细胞瘤鉴别,但不表达 CD38 和 MUM1 等浆细胞标志物。
分子标记:
CDH1 基因体细胞突变,导致 E-cadherin 表达缺失
鉴别诊断:
淋巴瘤 和浆细胞肿瘤 :浆细胞样尿路上皮癌多数仔细寻找总能找到原位或普通的浸润性尿路上皮癌成分,需要注意的是浆样尿路上皮癌可表达 CD138,易与浆细胞瘤混淆,免疫组织化学染色上皮标记阳性等可与淋巴瘤及浆细胞肿瘤鉴别。
转移性乳腺小叶癌:组织学相似且均表达 GATA3. GCDFP15. PR 等易混淆,仔细的结合病史并免疫组化染色标记 P63/P40,ER 以及 Mammaglobin 可资鉴别。
横纹肌样尿路上皮癌:瘤细胞胞浆更丰富,核仁明显,核旁可见嗜酸性中间纤维丝蛋白物球状聚集,Vimentin 显示核旁球状表达,部分病例可显示 INI-1 表达缺失。
预后:
侵袭性强,在诊断时 53-83%表现为 pT2 期以上、30%可见淋巴结转移。42%-80%在 TUR 标本中诊断的 pT1 期肿瘤在根治切除标本中分期上升到 pT2 期以上。总体生存率 3.8 年。5 年癌症特异性存活率 37%。约 12%复发为腹膜播散性癌病。
治疗:
根治性膀胱切除,对于经尿道切除诊断的浸润性浆细胞样尿路上皮癌,也应积极推行进行早期的根治性膀胱切除。
病例报道:
参考文献:
Plasmacytoid Urothelial Carcinoma of the Urinary Bladder: A Clinicopathologic and Immunohistochemical Analysis of 49 Cases.
Fox MD, Xiao L, Zhang M, Kamat AM, Siefker-Radtke A, Zhang L, Dinney CP, Czerniak B, Guo CC.
Am J Clin Pathol. 2017 May 1;147(5):500-506. doi: 10.1093/ajcp/aqx029. CD138 Expression Is Observed in the Urothelial Epithelium and in Various Urothelial Carcinomas, and Cannot Be Evidence for Plasmacytoid Urothelial Carcinoma.
Goto K.Int J Surg Pathol. 2016 Oct;24(7):614-9. doi: 10.1177/1066896916653673. Epub 2016 Jun 15. Am J Surg Pathol. 2009 Mar;33(3):417-24. doi: 10.1097/PAS.0b013e318186c45e.
Plasmacytoid urothelial carcinoma: detailed analysis of morphology with clinicopathologic correlation in 17 cases.
Nigwekar P, Tamboli P, Amin MB, Osunkoya AO, Ben-Dor D, Amin MB.
Al-Ahmadie HA, Iyer G, Lee BH, et al. Frequent somatic CDH1 loss-offunction mutations in plasmacytoid variant bladder cancer. Nat Genet. 2016; 48(4):356–358
Li Q, Assel M, Benfante NE, et al. The impact of plasmacytoid variant histology on the survival of patients with urothelial carcinoma of bladder after radical cystectomy [published online ahead of print June 27, 2017]. Eur Urol Focus. doi: 10.1016/j.euf.2017.06.013. Borhan WM, Cimino-Mathews AM, Montgomery EA, Epstein JI. Immunohistochemical differentiation of plasmacytoid urothelial carcinoma from secondary carcinoma involvement of the bladder. Am J Surg Pathol. 2017;41(11):1570–